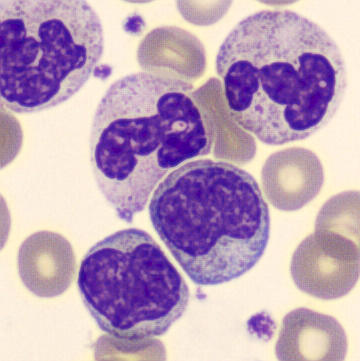
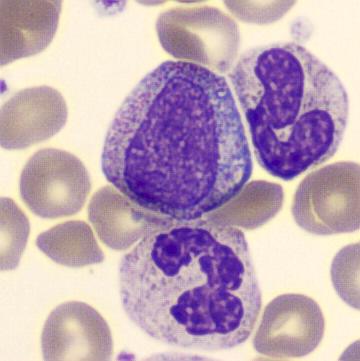

WDF - CML
SFL
SSC
Lymphocytes
Monocytes
Neutrophils
Eosinophils
Basophils
This plot shows a marked increase in the number of neutrophils , eosinophils and basophils . Thus, there is proliferation of multiple myeloid cell lines. Such a pattern, with simultaneous granulocytosis and basophilia, is strongly suggestive of a myeloproliferative disorder and is classically seen in chronic myeloid leukemia (CML). Although reactive causes can sometimes give neutrophilia or eosinophilia, the combination with pronounced basophilia is highly characteristic of CML.
Note that such, milder, patterns can also be seen in leukemoid reactions and in Transient Abnormal Myelopoiesis (TAM).
Morphology